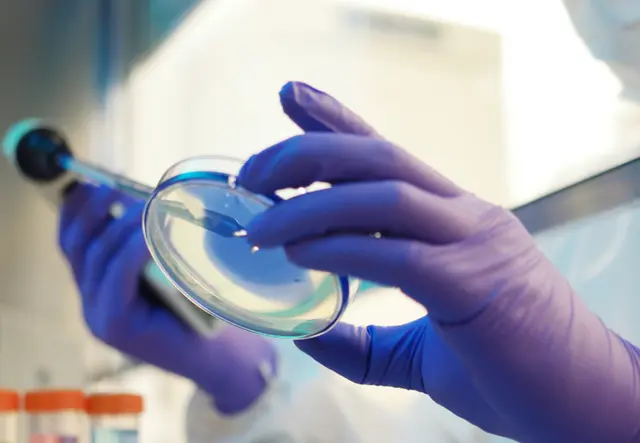

The Impact of Cleanroom Flooring Choices on Contamination Control

Choosing the right flooring is crucial for maintaining the stringent cleanliness standards required in cleanrooms. Flooring not only impacts the overall contamination control but also affects the operational efficiency and safety within these critical environments. This blog post explores various flooring options tailored for cleanrooms and assesses their influence on contamination risks. Why Flooring Matters […]
The Science Behind Cleanroom Ventilation Design

Effective ventilation is a cornerstone of cleanroom design, essential for maintaining air quality, controlling contaminants, and ensuring a stable environment for sensitive processes. This blog post examines the scientific principles that guide cleanroom ventilation design, the types of systems used, and how they contribute to achieving and maintaining the desired cleanliness levels. Fundamental Aspects of […]
Optimizing Cleanroom Layout for Maximum Efficiency

The layout of a cleanroom significantly impacts its operational efficiency, contamination control, and overall productivity. Strategic design considerations are essential for ensuring that cleanrooms not only meet the required cleanliness standards but also operate with maximum efficiency. This blog post explores the key aspects of cleanroom layout optimization, offering insights on how to best arrange […]
High-Efficiency Particulate Air (HEPA) Filters in Cleanrooms

HEPA filters are a cornerstone of modern cleanroom technology, crucial for maintaining the stringent air purity required in environments where even minuscule particles can lead to significant disruptions or product contamination. This blog post delves into the mechanics of HEPA filters, their critical role in cleanroom operations, and best practices for their maintenance and testing. […]
Contamination Risks in Cleanroom Environments

In cleanroom settings, where the smallest contaminant can compromise entire production batches or research outcomes, understanding and controlling contamination risks is paramount. This blog post explores the sources of contamination in cleanrooms and discusses comprehensive strategies to mitigate these risks, ensuring the purity and compliance of the environment. Sources of Contamination in Cleanrooms Contamination in […]
Decontamination Technologies for Emergency Response

In critical environments like cleanrooms, an unexpected contamination event can jeopardize operations, compliance, and product integrity. Decontamination technologies designed for emergency response play a vital role in quickly neutralizing contaminants, restoring cleanroom conditions, and minimizing downtime. This blog explores the advanced decontamination solutions available for cleanrooms facing emergency scenarios. The Importance of Rapid Response in […]
Advanced Techniques in Cleanroom Particle Monitoring

In the precision-driven realm of cleanroom environments, where even the smallest particle can compromise product integrity, the role of advanced particle monitoring techniques is critical. Employing sophisticated monitoring technologies, Vibraclean ensures that cleanrooms across industries like pharmaceuticals, biotech, and electronics maintain the highest standards of air quality and cleanliness. The Science of Particle Monitoring Particle […]
Precision in Particle Control: Vibraclean’s Advanced Filtration Systems
In controlled environments, the importance of advanced filtration systems cannot be overstated. HEPA (High-Efficiency Particulate Air) and ULPA (Ultra Low Particulate Air) filters are crucial in maintaining the sterility and compliance of cleanrooms across various industries. Vibraclean prides itself on implementing these systems, ensuring optimal air quality and particle control. Importance of Filtration in Cleanrooms […]
Critical Environment Decontamination: Beyond the Basics

In industries where sterility is paramount, such as pharmaceuticals, biotechnology, and semiconductor manufacturing, critical environment decontamination is essential. This process involves the removal of contaminants that could potentially compromise product quality and safety. Vibraclean utilizes advanced decontamination techniques to ensure these environments meet the highest standards of cleanliness. Decontamination Methods Decontamination in critical environments involves […]
Overview of Hydrogen Peroxide Fogging

What Is Disinfectant Fogging? Fogging is a better choice for facility sterilization. It can eliminate all contaminants in your cleanroom, even those hidden in hard-to-reach spots — between the floorboards, behind cabinets, or in the cracks between a row of desks. How Does Disinfectant Fogging Work? Disinfectant fogging starts with a solution of hydrogen peroxide […]











